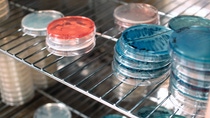

Locations
Littlehampton

The BASF Agricultural Specialities Limited production site in Littlehampton, acquired from Becker Underwood at the end of 2012, produces industry leading biological pest control products formulated from beneficial nematodes.
These products are used by farmers and growers across the globe in agricultural, protected ornamental and home and garden markets.
Liquid rhizobium inoculants produced at Littlehampton are used as seed treatments.
Petri dishes with cultures of symbiotic bacteria. They naturally occur in the nematode’s gut, but at the lab nature is given a helping hand by introducing the bacteria into the vessel in which the nematodes will be bred.

Each batch of nematodes starts out in a flask culture. These cultures are then used to seed the smaller fermenter vessels.
BASF Agricultural Specialities Limited
50/51 Eldon Way, Lineside Industrial Estate, Wick, Littlehampton West Sussex BN17 7HE